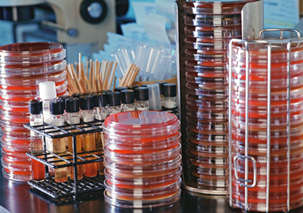
e1.medical.bacteria.cultures.spsec

In the November 2018 Issue
‘Forgotten Child’ of MS
Drug Ibudilast Slows Brain Shrinkage in Progressive Multiple Sclerosis
by Amy Norton
A drug that has long been used in Japan for asthma may slow down brain shrinkage in people with progressive multiple sclerosis, a preliminary trial has found.
The study, published Aug. 30 in the New England Journal of Medicine, tested an oral drug called ibudilast. It is not approved in the United States but has been used for years in Japan as a treatment for asthma and for vertigo in stroke survivors.
Researchers found that the drug slowed brain shrinkage by 48 percent when compared with an inactive placebo among patients with progressive MS.
Multiple sclerosis is a neurological disorder caused by a misguided immune system attack on the protective sheath around nerve fibers in the spine and brain. Depending on where the damage occurs, symptoms include vision problems, muscle weakness, numbness and difficulty with balance and coordination.
In the August 2018 Issue
Personal Breakthrough
Targeted Immunotherapy Seems to Rid Woman of Advanced Breast Cancer
by Alan Mozes
Judy Perkins was 49 and battling breast cancer that had spread, but chemotherapy and hormone treatments had failed to rein in her disease. So, her doctors tried a highly sophisticated but experimental, immunotherapy.
It worked beyond their wildest expectations: Her body was cleared of all signs of cancer. And the research team that tried the cutting-edge treatment hopes the case will herald a major breakthrough in cancer treatment.
The immunotherapy was tailored to the particular genetic mutations of Perkins’s tumor. In the end, the medical team identified 197 mutations. Of those, 196 were characterized as “unique” to Perkins.
In the November 2017 Issue
Human Toll of Pollution
Air, Water, Other Types of Pollution Tied to 9 Million Deaths Worldwide in 2015
by HealthDay News
Pollution led to more than 9 million deaths worldwide in 2015, or 1 in 6 deaths that year, a new report reveals.
Air pollution, the worst culprit, was linked to 6.5 million heart- and lung-related deaths, The Lancet Commission on Pollution and Health said.
Water pollution was tied to 1.8 million deaths, mostly from gastrointestinal and parasitic infections. And workplace-related pollution and lead pollution also played a role, contributing to 800,000 deaths and 500,000 deaths, respectively.
“Pollution is much more than an environmental challenge — it is a profound and pervasive threat that affects many aspects of human health and well-being,” said Dr. Philip Landrigan, co-lead of the commission.
Cancer and Weight
Obesity Linked to 13 Types of Cancer; Losing Weight May Lower Risk
by HealthDay News

There’s a link between obesity and 40 percent of all the cancers diagnosed in the United States, health officials reported Tuesday.
That doesn’t mean too much weight is causing all these cancer cases — just that there’s some kind of still-to-be explained association, according to the U.S. Centers for Disease Control and Prevention.
Still, the study findings suggest that being obese or overweight was associated with cancer cases involving more than 630,000 Americans in 2014, and this includes 13 types of cancer.
“That obesity and overweight are affecting cancers may be surprising to many Americans. The awareness of some cancers being associated with obesity and overweight is not yet widespread,” Dr. Anne Schuchat, CDC deputy director, said during a midday media briefing.
In the August 2016 Issue
Oversaturated
Study Cites the Fats That Could Shorten Your Life
by Robert Preidt (HealthDay News)
Hold the butter, margarine and high-fat dairy: A new study supports the notion that these “saturated” fats are bad for you.
The study, which followed more than 126,000 people for three decades, found that people who ate higher amounts of saturated fats and trans fats died earlier than those who stuck to healthier unsaturated fats.
Unsaturated fats include plant-based, unprocessed fats such as those found in olive, canola or soybean oil, the study authors explained.
“These findings support current dietary recommendations to replace saturated fat and trans fat with unsaturated fats,” concluded a team of researchers led by Dr. Frank Hu of Harvard School of Public Health in Boston.
Costs of Success
U.S. Cancer Survivors Living Longer
by HealthDay News

As the American population ages, more older adults will survive cancer and live with other chronic conditions that will burden the health care system, U.S. government health officials report.
“Increasingly, we are seeing the impact of an aging population — fueled by maturing baby boomers — on major diseases, including cancer,” said lead researcher Shirley Bluethmann, a cancer prevention fellow at the U.S. National Cancer Institute.
In 2016, nearly 62 percent of almost 16 million cancer survivors are ages 65 or older, the researchers said. By 2040, an estimated 73 percent of 26 million cancer survivors will be 65 or older.
In the May 2016 Issue
Zika and Pregnancy
U.S. Health Experts Debate Advice To Women Once Zika Virus Arrives
by HealthDay News
Following U.S. health officials’ announcement earlier this week that the Zika virus can definitely cause birth defects, many of those same experts are now locked in an unprecedented debate.
Should government health care officials recommend that American women delay getting pregnant in regions of the country once the mosquito-borne virus becomes active there?
So far, the virus in U.S. territories has been limited to Puerto Rico, the Virgin Islands and American Samoa. But as mosquito season approaches, health experts have said they expect to see infections in Gulf Coast states such as Florida and Texas, as well as Hawaii.
In the February 2016 Issue
Cost of Cancer
For Cancer Survivors, Expenses Keep Mounting
by HealthDay News
A cancer diagnosis is costly, and new research suggests that it remains costly even after the disease has been treated.
“Cancer survivors are facing high costs even after years. The economic burden is substantial,” said study author Zhiyuan Zheng, senior health services researcher at the American Cancer Society’s Surveillance and Health Services Research program.
For example, the study found that non-elderly survivors of colon cancer had extra expenses of about $20,000 annually. Those extra expenses included direct medical costs, as well as lost productivity. For survivors of breast cancer under 65, the economic burden totaled about $14,000, and for prostate cancer it was approximately $9,000, the research revealed.
In the November 2015 Issue
Dangerous Bacteria
Antibiotic Resistance Could Threaten Surgery, Chemo Patients
by HealthDay News
More people will die from common surgical procedures and cancer treatments if dangerous bacteria continue to develop resistance to widely used antibiotics, a new study warns.
Patients rely on antibiotics to protect them from potentially deadly infections after undergoing chemotherapy, pacemaker implantation, cesarean sections or countless other medical procedures, said study senior author Ramanan Laxminarayan. He is director of the Center for Disease Dynamics, Economics & Policy, a public health research organization in Washington, D.C.
The new study, published Oct. 15 in The Lancet, estimates that as many as half of infections after surgery and more than a quarter of infections after chemotherapy are caused by organisms already resistant to standard antibiotics.
If antibiotic resistance increases by just 30 percent in the United States, the tougher-to-treat bacteria could cause 6,300 more deaths a year and 120,000 more infections in patients undergoing either chemotherapy for cancer or 10 common surgical procedures, the researchers projected.
Rite of Passage
Should the Annual Physical Be Scrapped?
by HealthDay News

Doctors continue to debate the worth of a time-honored tradition of health care — the annual physical examination.
Some want the once-a-year physical abandoned, based on a growing body of research that these exams don’t reduce your overall risk of disease or death.
But yearly checkups help build the relationship between doctor and patient, leaving both better prepared when illness does strike, other doctors respond.
In editorials in the Oct. 15 issue of the New England Journal of Medicine, Harvard professors air both sides of the debate.
The original idea behind the annual physical examination held that these visits provide doctors an opportunity to practice preventive medicine, said Dr. Ateev Mehrotra, an associate professor of health care policy and medicine at Harvard Medical School in Boston.
In the August 2015 Issue
Lights Out
Time to Turn Lights Out And Get Good Night’s Sleep
by Gina Shaw
How much sleep do you need? Almost certainly more than you’re getting, according to new guidelines from the American Academy of Sleep Medicine (AASM).
Adults should be getting a minimum of seven hours of sleep per night in order to function well and avoid many chronic health conditions associated with lack of sleep, an academy panel recommended in an article published in June in Sleep magazine. In fact, sleep is so important that the academy said you almost can’t get too much of it. The panel did not put an upper limit on daily hours of sleep, saying that sleeping even nine hours or more regularly might be appropriate for some people, including young adults and those recovering from illness.
It’s become almost a competitive sport to lament/brag about how little sleep you’re getting, as a way of showing how busy or important you are. But it’s putting your health at risk, said panel moderator Dr. Nathaniel Watson, incoming AASM president. “Sleep is critical to health, along with a healthy diet and regular exercise. Our consensus panel found that sleeping six or fewer hours per night is inadequate to sustain health and safety in adults.”
In the May 2015 Issue
Ebola Epidemic
The Evolution of an Epidemic: Good News and Bad News on Ebola
by Gina Shaw

It’s a classic good news-bad news story. The good news? The Ebola epidemic is waning rapidly. During the first full week in April, just 30 cases of the disease were reported in all of West Africa. Numbers ticked up slightly the following week, to 37, but these figures are still by far the lowest weekly numbers of new cases since early in the epidemic, which began last spring. Even a few weeks ago, weekly new case reports ranged from the 120s to the 150s.
In Liberia, there have been no new cases of Ebola diagnosed since March, and the last person confirmed to have Ebola in that country died on March 27. In Sierra Leone, schools reopened on April 14 for the first time since classes were suspended at the height of the outbreak eight months previously (in Liberia they had opened in February).
In the February 2015 Issue
New Dimension
Expanding World of 3-D Printing Brings Tantalizing Medical Breakthroughs to Life
by Carolyn Cosmos

Outsize medical “miracles” can come in very small packages. In Ann Arbor, Michigan, a team of doctors and engineers saved an infant and a toddler in the last two years by inventing and implanting tiny expandable splints that hold their damaged airways open. Last Christmas in São Paulo, Brazil, an engineer and his daughters assembled and donated small artificial hands made out of plastic for children who couldn’t buy prosthetics.
On the other side of the world in China last year, an orthopedics professor created a rotating neck bone to replace a cancerous one in a young man’s spine. The artificial axis, which was made of powdered titanium and had no screws, was a perfect match. And in Stuttgart, Germany, an international team of experts invented a new micro-robot that is as wide as three human hairs and can swim through body fluids to deliver drugs.
What do these astonishments have in common? They were all the result of 3-D printing, a process by which successive layers of material are sprayed out to produce three-dimensional objects from a computer program. In each case, the life-saving or life-enhancing device was crafted on a printer.
In the November 2014 Issue
The Other “E” Outbreak
Surprising Rise of Enterovirus D68
by Gina Shaw

While you’re anxiously watching the news for the latest headlines about the Ebola outbreak, another sneaky infection has almost certainly hit much closer to home. It’s called enterovirus D68, and it’s flummoxed family physicians and public health officials alike with its rapid, pervasive spread throughout the United States.
“There are hundreds of enteroviruses out there. Every year, one or another will crop up here or there to create small outbreaks in a community,” explained infectious disease expert Dr. William Schaffner of Vanderbilt University School of Medicine. “It’s pretty unusual, although not unheard of, for them to spread throughout a whole state or region. It is very unusual for an enterovirus to kind of take over the whole country.”
But that’s just what EV-D68 has done. As of mid-October, outbreaks had been reported in at least 46 states and the District of Columbia. It’s not a new virus — the first time it was identified was in the 1960s — but it has only cropped up sporadically since then, and in very small numbers. “We don’t know why it chose 2014 to be the virus du jour, but it has certainly risen up, starting in the Midwest around Kansas and has since spread throughout most of the rest of the country,” Schaffner said.
In the August 2014 Issue
Chikun-What?
Caribbean Grapples With Nasty Mosquito-Borne Virus
by Gina Shaw
You might not be able to pronounce the name of the latest rampant mosquito-borne viral infection, but you’ll never forget chikungunya (chi-koon-goon-ya) if you catch it.
Commonly known as CHIKV (chick-vee), chikungunya first attracted notice last year in the Caribbean and has now spread to the United States as a very unpleasant souvenir of island vacations. It’s spread by the aedes aegypti mosquito, the same culprit that carries the more deadly dengue fever. Chikungunya isn’t as virulent, but the joint pain and fever it causes can make sufferers pretty miserable.
Chikungunya is actually a very old virus that was first identified in Tanzania in the 1950s. Scientists believe it evolved much earlier than that, around the year 1700. It doesn’t kill very often, with a fatality rate of about .4 percent (infants and the elderly are most vulnerable) compared to 1 percent to 10 percent for dengue. But the weeks of symptoms can be quite miserable, and for some people, chronic joint pain can persist for years after the initial illness subsides.
Healthy Collaboration
Bill & Melinda Gates Foundation Talks Global Health with Ambassadors
by Larry Luxner

SEATTLE — The world’s largest private charitable foundation, established by the richest but arguably most generous man in U.S. history, hopes to involve Washington-based diplomats in its efforts to improve health care throughout the developing world.
On June 27, the Bill & Melinda Gates Foundation hosted a panel discussion and lunch for 29 ambassadors visiting Seattle as part of a three-day “Experience America” visit organized by the State Department (see related story on page 6). The panel’s theme: “Seattle as a Global Health Hub” and “How Ambassadors Can Be Partners Abroad.”
The diplomats listened intently as topics ranged from the role of animals in food security to the development of vaccines to fight tuberculosis, AIDS and malaria.
In the May 2014 Issue
Move to Live
Research Hammers Home The Power of Exercise
by Carolyn Cosmos
Eat right and exercise — it’s a mantra doctors have been drilling into people for years. It’s also a tired refrain that most people probably tune right out. But an astonishing accumulation of research in recent years shows that exercise alone can add years and years to your lifespan — and that indolence and overeating are potentially far more fatal than anyone could have imagined.
When it comes to death and disease, “sitting is the new smoking,” warned Dr. Jeanne Marrazzo, a professor of allergy and infectious diseases at the University of Washington’s School of Medicine in Seattle. Rivaling tobacco use as a killer, “physical inactivity causes nearly 1 in 10 deaths worldwide, or over 5 million excess and preventable deaths each year.”
Marrazzo was speaking at the annual Conference on World Affairs, a weeklong forum on global issues held at the University of Colorado in Boulder. She was the first panelist at an April 9 session on health and exercise titled “Walk, Bike, Dance, Bend, Stretch and Run for Your Life.”
Marrazzo did not mince her words: “I see a lot of critically ill people,” she told the gathering, “and the number-one predictor of mortality is obesity.”
In the February 2013 Issue
ADHD in Girls
The Attention Deficit Disorder That Often Goes Unnoticed
by Gina Shaw
My oldest daughter, now 8, walked early, talked early, and read her first words when she was 4. She’s a bright and verbal little girl, but as she went from kindergarten into first grade, it became obvious that she was struggling with her schoolwork.
Reading even a page of a simple book became a battle. For a time at the beginning of second grade, she complained of difficulty seeing small letters so convincingly that we were sure she needed glasses. (A pediatric ophthalmologist soon proved otherwise.) She’d constantly lose her place in a book because she was trying to look ahead to see how many more pages she had to read. “A whoooole page?” she’d moan. Doing spelling practice, she’d misspell words that were right in front of her on the spelling list.
Then one day her second-grade teacher took me aside at a school function. She didn’t want to wait for parent-teacher conferences to talk to me. With a lot of extra help, our daughter was at grade level in reading but was falling behind in math. “I think your daughter may have attention deficit disorder,” she suggested.
Seeing Red
National Wear Red Day Spotlights Women’s Heart Health
by Larry Luxner

Feb. 7, 2014, marks 50 years since the Beatles first set foot in America, 110 years since the Great Baltimore Fire of 1904, and the inauguration of the XXII Winter Olympic Games in Sochi, Russia.
But for many Americans, the first Friday of this month stands out as a red-letter day for an entirely different reason: It’s National Wear Red Day, when both men and women across the United States plan to wear red in unison to call attention to women’s heart health. While breast cancer and its related pink campaigns often attract national attention, heart disease kills more women than all forms of cancer combined.
The program is sponsored by the Heart Truth, a project of the Bethesda-based National Institutes of Health. Since its founding in 2002 by NIH and the American Heart Association, the program’s symbol has been a stylized red dress. It’s aimed primarily at women ages 40 through 60, though younger women are also at risk for heart disease — especially if they’re of African or Hispanic descent.
In fact, says the American Heart Association, on average, Hispanic women are likely to develop heart disease 10 years earlier than other women. Despite that heightened risk, most are still unaware of the threat to themselves and their families. That’s why the campaign has lately been making a concerted effort to reach women in Spanish-speaking communities and tell them about this “silent killer” lurking in their midst.
In the November 2013 Issue
Health Away from Home
International Patient Programs Offer More Than Medicine
by Gina Shaw
When Saad (name changed to protect privacy) arrived in Washington, D.C., for the first time in 2009, he was 19 years old and terrified. Two years earlier, the young Saudi Arabian man had been diagnosed with a rare form of pancreatic cancer, a disease that usually strikes much older people.
“It was very slow growing but also very slow to respond to medication,” he said. After a course of chemotherapy and radiation at a Texas hospital, complications from surgery resulted in severe damage to his intestine. Saad was sent to MedStar Georgetown University Hospital for an intestinal transplant. “I came with my mom and dad, and I didn’t now anyone here,” he recalled. “I didn’t speak a word of English. I was in bad condition, and I was very frightened.”
Cosmetic Consequences?
Breast Implants and Cancer: Women Must Assess Risks
by Carolyn Cosmos

Does a woman’s desire to look and feel better about her body threaten the health of her body? This spring brought a storm of cancer-scare headlines for women with breast implants.
“Women with breast implants have nearly 40% greater risk of dying from breast cancer: study,” the New York Daily News said. “Breast Implants Can Hinder Breast Cancer Survival in Women,” Medical News Today announced.
The headlines were triggered by a survey published in the prestigious British Medical Journal in April. A meta-analysis (a review of existing research) found a 26 percent increased risk of discovering cancerous breast tumors later in women with cosmetic breast implants — that is, after the tumors had started to spread to other parts of the body. Additionally, these women had a 38 percent greater risk of death from breast cancer than women who didn’t have implants.
In the August 2013 Issue
Prevention 101
In Cancer’s Complex Journey, It’s Important to Start With Basics
by Carolyn Cosmos
When it comes to cancer, we often think of what happens after the diagnosis. There is the agonizing analysis of treatment options — from the Cadillac battle plan of chemotherapy, to the newer models of genetically targeted therapies and other cutting-edge advances. We pore over the latest clinical trials or the newest drugs. But many of us often lose sight of the basics in this age-old fight: how to prevent a cancer diagnosis in the first place.
Not all cancers, of course, are preventable. Some, like breast and ovarian cancer, can be tied to genetic mutations in certain people. In other cases, the reasons why cancer strikes otherwise seemingly healthy individuals can be a complete mystery.
But a large portion of cancer cases can, in fact, be prevented. The World Cancer Research Fund, for example, argues that the majority of cancer cases stem from environmental factors, many of them controllable.
While medical estimates typically hold that about a third of all cancers are due to outside factors like behavior and the environment, a few leading experts and researchers are venturing beyond those figures.
In the February 2013 Issue
Inova Fills Critical Gap
Comprehensive Cancer Care Coming to Northern Virginia
by Gina Shaw
It’s a surprising gap. For years now, the only National Cancer Institute-designated comprehensive cancer center in the Washington metropolitan area has been the Lombardi Cancer Center at Georgetown University. Both of Maryland’s NCI-designated cancer centers are in Baltimore (the University of Maryland’s Greenebaum Cancer Center and Johns Hopkins University’s Sidney Kimmel Cancer Center). Virginia’s are in Charlottesville and Richmond.
That’s only one comprehensive cancer center to serve a metropolitan area of some 5.8 million people, an area that is growing faster than any other Eastern Seaboard city, according to the 2010 census (3 percent between 2007 and 2009, compared with just about 1 percent for New York, Philadelphia and Baltimore). The Philadelphia metropolitan area, by contrast, has four cancer centers for a similarly sized population; greater Boston, with about 4.5 million people, has two.
Human Subjects
African Bioethicist Urges More Oversight for Clinical Trials
by Carolyn Cosmos

A few years ago, medical ethics expert Paul Ndebele, a noted African scholar, saw something at a malaria research site in Malawi that disturbed him: The project was using junior staff as bait to collect mosquitoes for research colonies and feeding the malaria-carrying insects human blood — straight from the source.
When the staffers offered their arms at mosquito mealtimes, they naturally risked infection, Ndebele said, warning that those who continued doing this while taking drugs to prevent or treat malaria were potentially sparking malarial drug resistance in mosquito populations.
Using humans as insect bait — a practice that has its own scientific label, Human Landing Catch (HLC) — is considered the most effective way to capture adult mosquitoes, but Ndebele questioned the ethics of it in an article for the Malawi Medical Journal in 2011.
In the August 2012 Issue
Almost…
For Pregnant Women, 40, Not 37, Is Magic Number
by Gina Shaw
When I was preparing to deliver my younger daughter in 2010 at New Jersey’s Morristown Hospital, my midwife told me about a new rule there: no elective inductions of labor or C-sections before 39 completed weeks of pregnancy. If a woman or doctor wanted labor induced or a C-section scheduled before the magic 39-week mark, they would have to present the hospital with a legitimate medical reason why it was better to evict the baby early instead of letting things get closer to the 40 weeks that constitutes a completed pregnancy.
In the May 2012 Issue
Critical Activity
For Mother’s Day, Doctors Advise Women to Take Exercise to Heart
by Gina Shaw
How much “moderate to vigorous” exercise do you get a day? According to new research, if you’re an average woman, you get about 18 minutes, compared with 30 minutes for men. That relative inactivity puts women at an increased risk for a nasty constellation of factors known as the “metabolic syndrome,” including high blood pressure, high cholesterol and excess weight around the waistline. In turn, the metabolic syndrome boosts your risk of life-threatening conditions like type 2 diabetes, stroke and heart disease.
In a study published March 31 online in the journal Preventive Medicine, researchers from Oregon State University in Corvallis reported the results of a national study of physical activity, depression and other symptoms in more than 1,000 men and women, using data collected between 2005 and 2006 as part of the well-known National Health and Nutrition Examination Survey (NHANES).
In the February 2012 Issue
Targeted Progress
Breast Cancer Research Holds Potential for Subsets of Patients
by Gina Shaw
During the month of October, everything from tennis balls to eyelash curlers to handguns is painted pink for “breast cancer awareness.” (Is there anyone left who isn’t aware of breast cancer?) Newspapers, websites and broadcast outlets run ceaseless headlines about the latest breast cancer stories.
But the real news in breast cancer doesn’t come in October. Instead, it comes two times a year: in June, at the annual meeting of the American Society of Clinical Oncology (ASCO), and in December, when researchers converge on Texas for the San Antonio Breast Cancer Symposium. Let’s take a look at what exciting new findings came out of San Antonio at the end of 2011.
Protection, Not Promiscuity
Research Debunking Fears That HPV Vaccine Leads to Sexual Activity
by Gina Shaw

Good news, parents of teenage girls: If you and your daughter make the decision that it’s a good idea for her to get the vaccine against the human papillomavirus (HPV), a sexually transmitted infection that is the leading cause of cervical cancer, she’s probably not going to turn into a raging nymphomaniac.
OK, so they didn’t put it exactly like that, but that’s the basic conclusion of a new study published in the American Journal of Preventive Medicine. Researchers involved with the Centers for Disease Control and Prevention’s National Survey of Family Growth (NSFG) studied 1,200 women between the ages of 15 and 24 regarding their sexual education and behaviors, and found that young women who’ve had the vaccine are no more likely to be sexually active, or to have had multiple partners, than those who didn’t get the vaccine.
In the November 2011 Issue
Wounds of War
U.S. Soldiers on Front Lines Of Traumatic Brain Injury Research
by Gina Shaw
Photo: Emrah Turudu / iStock
A land mine explodes near an armored vehicle on the battlefield in Afghanistan. The soldiers inside see a blinding flash and hear a deafening noise. Dazed, they grab their weapons and continue the battle. They assume they’re fine. But they might not be.
Over the next few days and weeks, the soldiers may realize that they’re having trouble with their memory and concentration, suffering from mood swings, feeling constantly irritable and having trouble sleeping — all hallmarks of a condition called traumatic brain injury.
Traumatic brain injury has become known as the “signature injury” of the Iraq and Afghanistan wars, due in large part to blast exposures from improvised explosive devices (IEDs), suicide bombers, land mines, mortar rounds and rocket-propelled grenades.
Heart of the Matter
Statins: Widespread and Beneficial, But Not Benign Wonder Drugs
by Gina Shaw
Photo: David Watkins / BigStock
Statin drugs are big business in America — and all over the world. These cholesterol-lowering medications can be found in millions of medicine cabinets. Indeed, half of all men over 65, and about 36 percent of women in the same age group, take a statin drug, according to the National Center for Health Statistics. The Centers for Disease Control and Prevention reports that one out of every four Americans over 45 is taking a statin. That’s more than 30 million people.
Statins appear to have a host of benefits beyond just lowering “bad” (LDL) cholesterol levels and reducing the risk of heart disease. Two major studies published in the journal Cancer Causes and Control recently suggest that high cholesterol is linked to the development of prostate cancer, and that men taking statins have a decreased risk of getting prostate cancer.
In the August 2011 Issue
Promise of PARP
Enzyme Inhibitor Offers Exciting New Option in Ovarian Cancer Treatment
by Gina Shaw
Photo: Andy Nowack / iStock
Ovarian cancer is extremely difficult to diagnose and treat. Its symptoms are often confused with other, more benign conditions like gastrointestinal problems, and by the time the disease is recognized, seven or eight out of every 10 patients already have advanced-stage cancer where survival rates are low.
Last year, according to the National Cancer Institute, there were more than 21,000 estimated new cases of ovarian cancer in the United States and 13,850 deaths. Unfortunately, even when there is a good response to initial treatment, between 70 percent and 90 percent of women with ovarian cancer eventually have a recurrence of their disease. “Ovarian cancer is often a chronic disease,” said Dr. Barbara Goff, director of gynecologic oncology at the University of Washington and the Seattle Cancer Care Alliance. “So we need to find agents that keep the disease from growing, and at the same time are relatively nontoxic.”
Out of This World
Space-Pioneered Ultrasound Technology Sparks Terrestrial Health Care Advances
by Carolyn Cosmos
Photo: NASA
While the end of NASA’s 30-year space shuttle program that carried astronauts into orbit is mourned, or perhaps applauded by some, its demise may be greatly exaggerated. Not only does NASA have its eye on deep-space missions to places like Mars, private companies, largely funded by the space agency, will still propel astronauts into Earth’s orbit. But perhaps one of the most indelible imprints the program has left on mankind is the science developed aboard shuttle flights and the International Space Station — which may be transforming the lives of people back on Earth.
In fact, as the Atlantis space shuttle lifted off from Florida’s coast on July 8, a remarkable scenario was unfolding along the Pacific coast of Nicaragua in a region called Tola. Two days after the launch, an international team descended on the rural town of Las Salinas to deliver a health care technology that had its genesis on the International Space Station.
In the May 2011 Issue
RoboDoc
Meet the Machine Who May Be Performing Your Next Surgery
by Carolyn Cosmos
Photo: Boulder Community Hospital
Dr. Christopher Pohlman, a physician at Boulder Community Hospital in Colorado, specializes in minimally invasive surgery, operating through tiny openings in his patients. But those incisions aren’t done with a traditional scalpel by hand. And Pohlman doesn’t hover over the body when the cuts, exploration and surgical repair are done inside his patients.
Rather, his second-hand man — or in this case, machine — does the work while Pohlman guides the robotic “hands” from a high-tech console nearby. The hardest part of doing general surgery with a robot is positioning the patient, Pohlman told The Washington Diplomat. The robot’s four long instrument-like arms stretching down from its towering body have to be placed just so. “It’s like docking a space station.”
Price Palpitations
Exorbitant Drug Costs May Price Out Patients
by Gina Shaw
Photo: BigStock
In January, an injectable form of the drug progesterone, a synthetic hormone used to prevent preterm labor in some 130,000 pregnant women every year, cost as little as $10 from your local pharmacy.
Just three months later, the same drug skyrocketed to $1,500 per dose — although after a public outcry, the price tag dropped to $690 per dose. That’s still a 69-fold price increase. Why? Did the drug magically get better? Did manufacturers discover a brand new indication? Nope.
The Food and Drug Administration granted exclusive approval to KV Pharmaceutical to produce the drug under the brand name Makena, designating it an “orphan drug” with seven years of monopoly protection. The agency decided that because the drug is a sterile injectable drug, granting specific approval to a manufacturer under FDA guidelines would offer a greater assurance of safety.